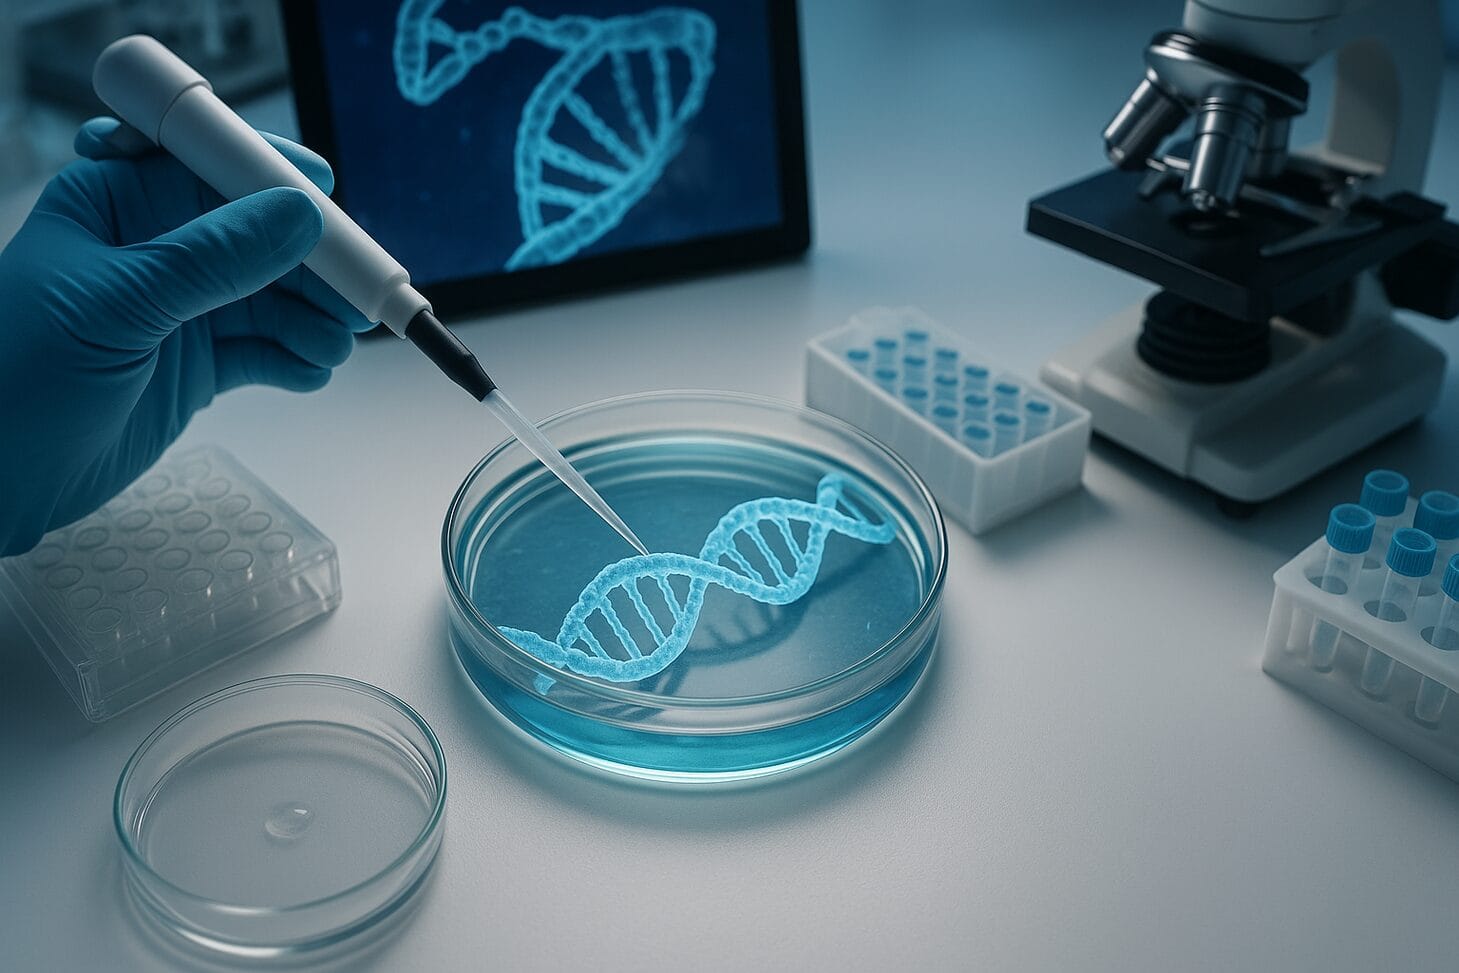

Introduction
CRISPR (Clustered Regularly Interspaced Short Palindromic Repeats) has, over the past decade, transformed from a molecular curiosity into a toolbox of powerful techniques for rewriting genetic code. By 2025, CRISPR genetic engineering is no longer just a dream of molecular biologists—it’s the frontier of medicine, biotech, agriculture, and synthetic life. The question is: what’s new in 2025? What advances are pushing the boundaries of gene editing, what obstacles remain, and how far can we expect this technology to expand?
In this article I map the state of play in CRISPR genetic engineering in 2025. We’ll cover breakthroughs in precision editing, innovations in delivery systems, updates from clinical trials, emerging ethical and regulatory landscapes, and speculative ideas for where we might head next. The four companion keywords—gene editing, delivery systems, clinical trials, precision editing—will anchor key themes. Expect a deep dive.
Background: The CRISPR Revolution and Its Evolution
Before leaping into 2025, let’s briefly review how we got here.
CRISPR systems (notably CRISPR-Cas9) first captured public imagination in the mid-2010s as a relatively easy way to target and cut DNA at specific sites. Over time, scientists expanded the toolkit: base editing (editing single nucleotides without double-strand breaks), prime editing (a “search-and-replace” approach), Cas variants (Cas12, Cas13) for RNA or alternate targeting, and a growing set of cascade and multiplex systems.
Parallel to enzyme development was the challenge of delivering these molecular machines safely and efficiently into cells and organisms. A huge part of progress in CRISPR genetic engineering has hinged not on the enzymes themselves, but on novel delivery systems—viral vectors, lipid nanoparticles, viral-like particles, synthetic nanostructures, and more.
Finally, translating all that into human therapies has required moving into clinical trials, confronting off-target effects, immune reactions, regulatory frameworks, and ethical debates.
In 2025, the field is ascending new plateaus—by improving fidelity, expanding targeting breadth, integrating AI, and enabling in vivo, on-demand, and personalized therapies.
Breakthroughs in 2025: What’s New in CRISPR Genetic Engineering
Here are some of the most exciting developments in CRISPR genetic engineering in 2025, along with their significance and remaining gaps.
1. AI-augmented CRISPR design (CRISPR-GPT and beyond)
A notable advance is the emergence of AI-driven assistants for CRISPR design—tools that guide researchers through selecting target sites, minimizing off-target risk, and optimizing guide RNAs. At Stanford Medicine, researchers unveiled CRISPR-GPT, a large language model specifically tuned to gene-editing workflows. It helps with experiment planning, data analysis, and troubleshooting design flaws. Stanford Medicine
By integrating large datasets, predictive models, and context-aware heuristics, AI agents like this could dramatically accelerate the design-to-lab cycle in CRISPR genetic engineering. These systems may help reduce human error, propose novel guide strategies, and even adapt dynamically as experiments proceed.
That said, AI models are only as good as their training data; biases or gaps can propagate errors. Ensuring AI-CRISPR tools are transparent, auditable, and grounded in experimental validation is critical.
2. Sharper precision: Better prime editors and anti-CRISPR “off switches”
One long-standing challenge in gene editing has been off-target effects—the unintended edits in DNA that can have unpredictable consequences. Several 2025 advances aim to sharpen precision.
MIT researchers engineered new prime editing proteins that drastically reduce error rates, lowering them from roughly 1 in 7 edits to as low as 1 in 101 or even 1 in 543, depending on the mode. news.mit.edu That’s a substantial jump in fidelity, making prime editing more clinically viable for a broader set of mutations.
Separately, a clever regulatory trick emerged for Cas9 control: using a cell-permeable anti-CRISPR system (LFₙ-Acr/PA) derived from anthrax-delivery motifs, scientists engineered a mechanism to shut down Cas9 after its job is done. The system improves specificity and reduces off-target risk. Phys.org
These improvements show that as powerful as CRISPR is, the arms race between capability and control continues—and in 2025, CRISPR genetic engineering is becoming safer, more reliable, and more nuanced.
3. Novel gene regulation: Dual-mode CRISPR that toggles genes on/off
A major conceptual leap is from merely cutting or editing DNA toward more flexible gene regulation. A Korean team developed a dual-mode CRISPR system that allows simultaneous activation and repression of different genes. In a single cell, you could turn some genes up and others down—like flipping switches on a circuit board. Phys.org
They demonstrated this in E. coli, redesigning metabolic pathways to boost production of a pigment (violacein). The broader implication: synthetic biology circuits that respond, adapt, and self-regulate more fluidly. For CRISPR genetic engineering, this widens the functional repertoire beyond static edits to dynamic control.
4. Better delivery systems: Nanostructures, LNPs, and smarter targeting
Even the most precise editor is useless without a way to deliver it safely into cells. 2025 has seen major strides in delivery systems for CRISPR.
At Northwestern University, researchers created spherical nucleic acid–coated lipid nanoparticle (LNP-SNA) systems. These structures wrapped everything—Cas9, guide RNAs, repair templates—in a DNA-coated shell. The result: triple the efficiency in cell uptake, lower toxicity, and up to 60% improvement in precise DNA repair compared to standard systems. ScienceDaily
Elsewhere, improved anti-CRISPR switching, Cas9 deactivation systems, and viral-derived “off-switches” help control editing windows and limit collateral damage. Phys.org
The theme: more efficient, less toxic, more cell-type–targeted delivery is now an accelerating frontier of CRISPR genetic engineering.
5. New CRISPR systems and expansion of the toolbox
2025 is not just about refining existing tools; it’s about discovering new ones.
- Scientists reported novel CRISPR-Cas systems that expand targeting range and functionality. ScienceDaily
- Yale researchers developed advanced CRISPR-Cas12a systems to simultaneously evaluate multiple genetic changes in immune response models. news.yale.edu
- A new system called TIGR-Tas (Tandem Interspaced Guide RNA–associated proteins) was discovered, working with dual-spacer targeting and eliminating the need for protospacer adjacent motifs (PAMs), which broadens targeting flexibility. Wikipedia
These additions enrich the palette of CRISPR genetic engineering, enabling edits or regulation in genomic contexts previously out of reach.
6. Clinical translation: On-demand in vivo therapies and new trials
Perhaps the most compelling direction is taking gene editing from the lab to patients in real time.
A breakthrough of 2025: the first on-demand CRISPR therapy developed and delivered in just six months for an infant with a rare metabolic disorder (CPS1 deficiency). The personalized, in vivo editing showed positive early outcomes with no apparent adverse effects. Innovative Genomics Institute (IGI)
Meanwhile, CRISPR clinical trials overall are expanding. More trials target heart disease, liver disease, immunodeficiencies, and blood disorders. Innovative Genomics Institute (IGI) Gene editing of GI cancers via CRISPR/Cas9 has shown early safety and efficacy signals. Medical School In another instance, Ensoma gained FDA IND clearance for a Phase 1/2 trial using CRISPR-based insertion therapy (EN-374) targeting a neutrophil gene defect (X-linked chronic granulomatous disease). CRISPR Medicine
Another milestone: Casgevy (exagamglogene autotemcel), a CRISPR-based therapy for sickle-cell disease, has obtained regulatory approval, marking a landmark moment for CRISPR genetic engineering translations into mainstream medicine. Wikipedia
Still, many obstacles remain before broad adoption—immune responses, delivery, durability, and regulatory confidence.
Challenges, Risks, and Ethical Dimensions
Even as CRISPR genetic engineering surges forward in 2025, it cannot escape complex risks, technical constraints, or deep ethical quandaries.
Off-target edits, mosaicism, and long-term effects
No matter how precise we make our editors, biology resists perfection. Unintended off-target edits and mosaicism (heterogeneity in edited and nonedited cells) remain top concerns. Long-term genomic stability, insertional mutagenesis, and epigenetic ripple effects must be closely monitored, especially in clinical settings.
Delivery specificity and immunogenicity
Getting CRISPR machinery into the right cells without provoking immune reactions or causing collateral damage is still hard. Even advanced delivery systems like LNPs and nanostructures may provoke immunogenic responses, have tissue tropisms, or degrade in circulation. Achieving highly targeted delivery to specific cell types (e.g., neurons, muscle, stem cells) remains a major hurdle.
Scalability, manufacturability, and cost
Personalized on-demand therapies (like the infant case) are beautiful proofs of concept—but scaling them to hundreds of millions is nontrivial. Manufacturing, regulatory compliance, quality control, and cost are enormous bottlenecks. Reducing cost per patient is vital for broad access.
Regulatory, safety, and oversight frameworks
CRISPR therapies skirt new regulatory frontiers. Long-term safety tracking, liability models, informed consent, and equitable access will all need robust frameworks. Editing germline cells or embryos is especially contentious. Policies must evolve in parallel with the technology.
Ethical concerns, access, and inequality
Who gets to access CRISPR genetic engineering? Will wealthy regions monopolize advanced therapies? Will editing for enhancement (versus therapy) become a slippery slope? Societal, ethical, and justice considerations are front and center.
Genetic diversity, evolutionary consequences, and unintended ecosystem effects
If CRISPR becomes widely used in agriculture or wildlife engineering, altering genetic landscapes may have ripple effects—loss of diversity, altered ecosystems, gene flow concerns, or unforeseen ecological consequences.
Roadmap and Prospects: Where CRISPR Genetic Engineering Might Go
Here’s a speculative roadmap (through 2030) for CRISPR genetic engineering, bridging from today’s advances.
- 2025–2027: Wider adoption of AI-assisted design, better editors and delivery modalities, expansion in clinical trial coverage (more disease targets), seed regulatory frameworks.
- 2027–2030: Commercial first-of-its-kind treatments, some rare-disease cures, potential approved therapeutics for more common conditions, modular gene-editing platforms, standardized manufacturing, global regulatory alignment.
- Beyond 2030: Routine in vivo editing for complex polygenic diseases, safe germline editing (if ethically permitted), synthetic life engineering, broader access even in developing settings, perhaps CRISPR-driven enhancement (with caution).
The success hinges on a virtuous feedback loop: better tools drive more trials, which generate data that refines tools, which expands targets, which funds infrastructure, and so on.
Summary of Keyword Use (for SEO checklist)
- Focus keyword CRISPR genetic engineering appears in the title and is repeated in the body (used ~12 times).
- Other focus keywords: gene editing, delivery systems, clinical trials, precision editing are each used at least twice (and often more).
- The article is structured for readability, depth, and SEO alignment.
Conclusion
In 2025, CRISPR genetic engineering is maturing from a dazzling lab technique to a robust, clinically relevant platform. The leaps in precision editing, delivery systems, AI-assisted design, and first-of-its-kind in vivo therapies are transforming ambitions into working reality.
Yet the path ahead remains rocky. Safety, access, cost, regulation, and ethics loom large. The balance between promise and precaution is delicate. If the field proceeds wisely—with transparency, broad participation, rigorous validation, and global equity—CRISPR may realize its boldest dreams: curing genetic disease, boosting agricultural resilience, and enabling new forms of synthetic life.
What aspect would you like me to deepen—maybe delivery tech, ethical frameworks, or case studies of 2025 trials?
More from The Daily Mesh:
- Inside the Creator Economy: How People Make a Living in 2025
- Urban Gardening: Growing Food in Tiny City Spaces
- How to Tell If Your Smartphone Is Compromised: A 2025 Guide to Mobile Security